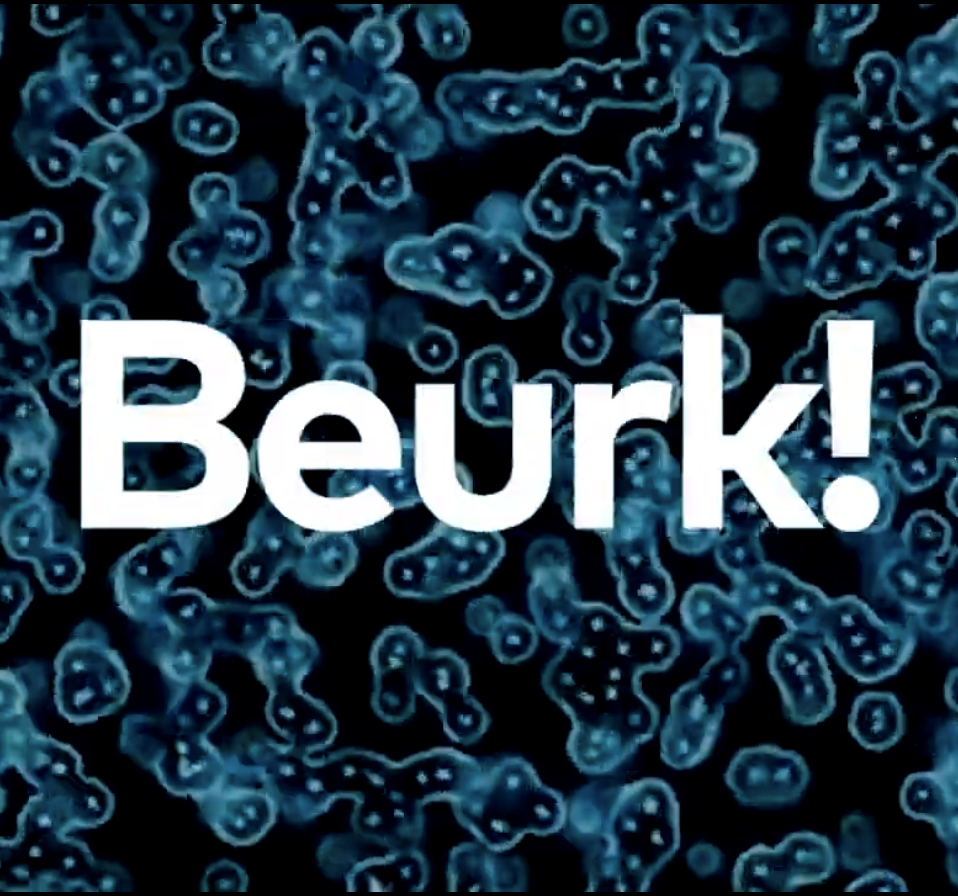

Motion Graphics
Below is a short teaser video showcasing standout design projects from my portfolio, featuring work across the CPG, beauty, and food industries. The piece highlights packaging design, motion graphics, and brand storytelling that capture the creativity and technical precision.
I collaborated with national and international marketing teams at Waterpik to create motion graphic projects that educated consumers on the health benefits of using a Waterpik water flosser to prevent gingivitis and plaque buildup. Utilizing kinetic typography and advanced video editing, I produced short, impactful videos that combined dynamic text animation with visual storytelling, making key messages about oral hygiene engaging and memorable while highlighting Waterpik’s role in promoting better dental health.
This short animation, titled Animated Portrait, presents a hyperrealistic digital figure rendered with striking cinematic lighting and painterly precision. The subject—an elegant young woman with auburn hair, luminous skin, and vivid red lips—turns her expressions to life. A wash of green light softly transitions across her face, contrasting with the magenta undertones in her hair and background, evoking a mood both futuristic and intimate. Created as part of my portfolio exploration in AI-assisted digital portraiture and animation, this work demonstrates technical mastery in lighting, color grading, and emotional nuance within short-form motion design.